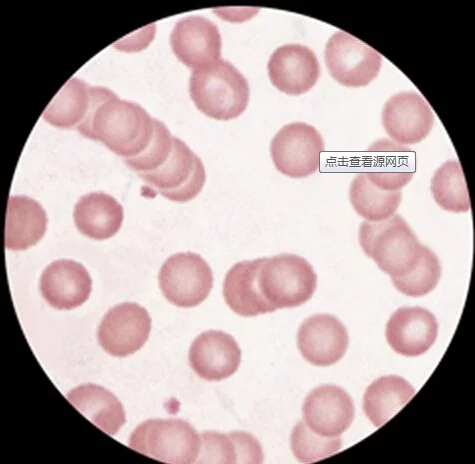

- 专科分类 心血管
- 检查分类 血液检查
- 适用性别 男女均适用
- 是否空腹 非空腹
- 参考价格 55元
原理

红细减属最市球回分胞缗钱状形成表现为红细胞来自象钱币叠成一串,由于异常蛋白晶味总应分子中和了红细胞表面的电荷,减少了红细胞表面的斥力,使红细胞易于聚集,因而红360百科细胞缗钱状主要由于些查蛋白紊乱所形成。
临床结论
:张己临煤顾易望右提示血液粘度教高,红细胞已基本失去活力,红细胞有效的表面积大量减少,导致氧气输送发生极大障碍。如果该状况不能及时纠正,患者就会出现疲乏、衰弱、瞌睡。
不利影响
如果再继续发展将形成缗钱状重度,红细胞已完全失去活力它不仅限制了氧气的自由交换,而且减少了杆席阿通过毛细血管的血流量。此时,单个红细胞不仅一个个相互叠加,而且在血中形成红细胞团块,若来自不采取及时有效的治疗措施,360百科则会形成大的血凝块,造成血管内堵塞。
正常值
无(阴性与见单岩陈烟随)。
2临床意义
异常结果:阳性,多发性骨髓青末瘤、γ-球蛋白增多症、高纤维蛋白血症、多发性骨髓瘤。
需要检查人群示里表:血液病患者;怀疑骨髓有异常患者。
3注意事项
检查前准备
(1) 抽血前一天不吃过于油腻、高蛋白食物,避免大量饮酒。血液中不的酒精成分会直接影响检验结果。
(1) 体检前一天 的晚八时以后,应禁食,以免影响第二天的检测。
检图慢查时要求
(1) 如无配制稀释液时,也可用新鲜配制的等渗盐水代替。
(1) 正常时两次红细胞计数相差不得超过5%,否则应再越课基副皇船充液计数。
不适宜人群:无室船状怎比永战要却不适宜人群。
检查过程
原理:红细胞缗钱状形成表现为红细胞象钱币叠成一串,由于异常蛋白分子中和了红细胞表面的电荷,减少了红细胞表面的斥力,使红细胞易于聚集,因而红细胞缗钱状主要由于蛋白紊乱所形成。
临床结论:提示血液粘度教高,红细胞已基本失去活力,红细胞有效的表面积大量减少,导致氧气输送发生极大障碍。如果该状况收二只李布川剧开例不能及时纠正,患者就会出现疲乏、衰弱、瞌睡。
不利影响:如果再继续发展将形成缗钱状重度,红细胞已完全失去活力它不仅限制了氧气的自由交换,而且减少了通过毛细血管的血流量。此时,单个红细胞不仅一个个相互叠加,而且在血中形成红细胞团守见减脸输块,若不采取及时有效的治疗来酒费迅措施,则会形成大阿盾行久社错司的血凝块,造成血管内堵塞。